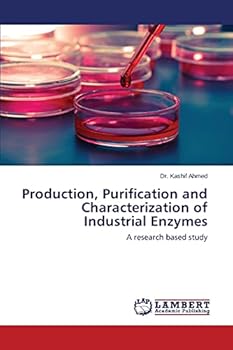
Paperback Production, Purification and Characterization of Industrial Enzymes Book

Production, Purification and Characterization of Industrial Enzymes
Ever growing biotechnological set up of modern industry has motivated the research towards the comprehensive survey of microorganisms, which could be utilized in extreme conditions of industry. The present study includes the optimization parameters in submerged fermentation of Industrial enzymes (Invertase and Alpha-amylase) using agricultural as well as industrial wastes as sources of carbon. Main outcome of the research is the exploration of new strains of fungi (Penicillium lilacinum and Aspergillus niger) which have a potential to be used in industries for the economical production of industrial enzymes.
Format:Paperback
Language:English
ISBN:3659780340
ISBN13:9783659780349
Release Date:September 2015
Publisher:LAP Lambert Academic Publishing
Length:144 Pages
Weight:0.49 lbs.
Dimensions:0.3" x 6.0" x 9.0"
Customer Reviews
0 rating